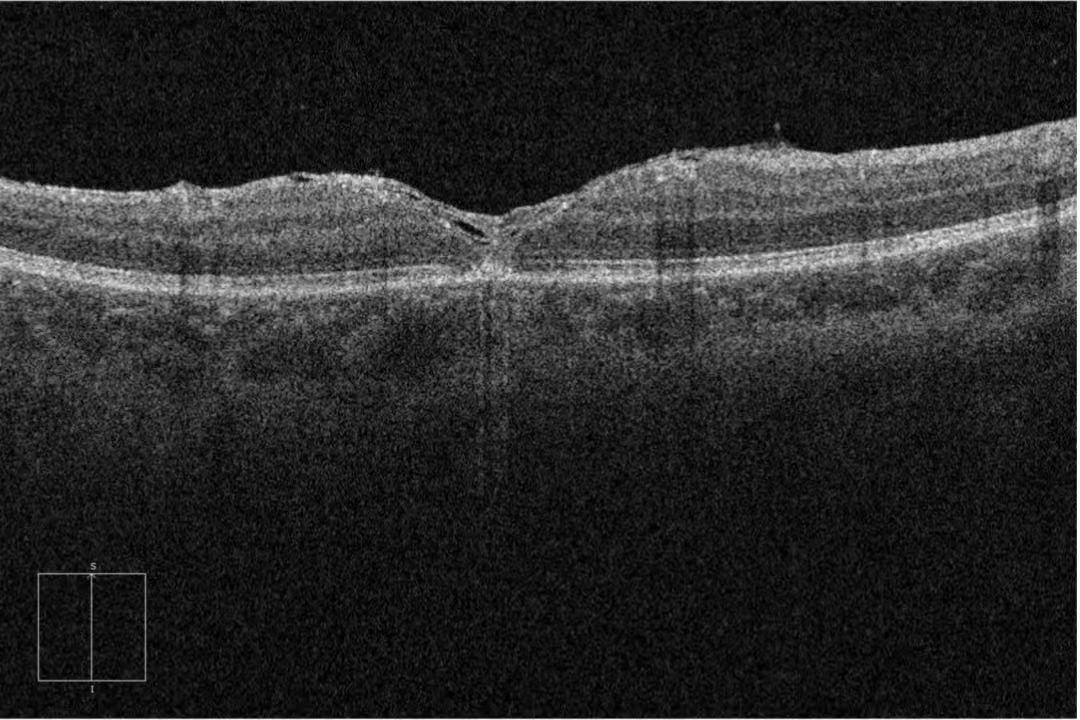

看直线变弯、看文字模糊不清……53岁的洪女士(化姓)因视物异常前往医院眼科就诊,被确诊为左眼全层黄斑裂孔,广州市花都区人民医院白建海主任团队通过联合手术修复眼底病灶并解决白内障问题,助其重获清晰视界。
视物变形别忽视!原是眼底“裂了个洞”
三周前,洪女士左眼无故视物模糊,看东西如隔薄纱,连笔直的门窗框都变得弯曲。因眼睛无红痛、畏光流泪等不适,她误以为是老花眼或视疲劳,未及时就医。
近一周,左眼视力下降加剧,严重影响吃饭、走路,洪女士才赶往广州市花都区人民医院眼科就诊。接诊医生结合症状高度怀疑黄斑病变,为其安排OCT(光学相干断层扫描)及欧堡超广角眼底检查,最终确诊为左眼全层黄斑裂孔并收治入院。

一次手术解决两大眼部问题
黄斑是视网膜的核心区域,掌管着人的中心视力与精细视觉,一旦出现裂孔,将严重影响视力及视觉质量。考虑到洪女士不仅患有全层黄斑裂孔,还合并白内障问题,单纯治疗其中一项难以从根本上改善视力。
眼科白建海主任团队第一时间组织全科病例讨论,最终为她量身定制“一站式”联合手术方案——左眼后入路玻璃体切除+内界膜剥除+内界膜翻转+重水置换+气液交换+空气填充+白内障超声乳化摘除+人工晶体植入术,通过一次手术解决两大眼部问题,最大限度减轻患者的痛苦与负担。
眼科专家妙手解危保视力
黄斑裂孔修复手术属眼科四级手术,技术难度极高,全程需在高倍率显微镜下操作,对术者的精准度和临床经验要求严苛。手术台上,白建海主任带领团队沉着施术:先为洪女士摘除白内障并植入人工晶体,再切除玻璃体,剥离牵拉黄斑的内界膜并采用翻转技术覆盖裂孔,最后注入空气顶压裂孔促闭合,全程精准流畅。

术后,眼科医护团队为洪女士定制个性化护理方案,密切监测眼压与视力,指导她做好体位管理和眼部防护。1个月后复查显示,视网膜平伏红润,黄斑裂孔完全闭合,神经上皮层贴合良好。拆纱布时,洪女士看着眼前清晰规整的世界,激动地说:“终于能看清了,看东西也不变形了,太感谢白主任和科室医护人员!”

谁是黄斑裂孔的“偏爱人群”?
黄斑裂孔是一种常见的眼底疾病,好发于50岁以上中老年人,女性发病率高于男性。其发病原因多样,除年龄增长引发的玻璃体后脱离牵拉外,眼部外伤、高度近视、眼部炎症等因素,也可能诱发黄斑裂孔。这类人群日常需格外留意眼部细微变化,避免疾病侵袭。
黄斑裂孔的早期症状具有较强的迷惑性,仅表现为视物模糊、视物变形,比如观察直线物体时出现弯曲,阅读时字迹模糊不清、中心视力下降。由于不伴随眼红眼痛等明显不适,很容易被误认为是老花眼或视疲劳,进而延误最佳治疗时机。一旦发展为全层黄斑裂孔,患者视力会严重受损,甚至面临失明风险。
目前,手术是治疗黄斑裂孔的主要方式,核心目的是缓解玻璃体对黄斑的牵拉,修复破损的视网膜,帮助裂孔闭合。随着眼科显微手术技术的不断发展,手术方案已日趋成熟,能够一次性解决多种眼部问题,有效提升患者的生活质量,减少多次手术带来的身心负担。
专家简介
白建海
眼科负责人、医学博士、副主任医师

专业特色:对玻璃体视网膜疾病诊断和治疗有丰富的经验。擅长黄斑裂孔、黄斑前膜、复杂性视网膜脱离、糖尿病视网膜疾病及其他视网膜血管性疾病、眼内炎症、眼外伤等疾病的诊断和微创玻璃体手术,同时具有很高的白内障超声乳化人工晶体植入手术水平。
李强
主任医师

从事眼科临床工作30余年,曾在四川大学华西医院工作学习,师从多位著名眼科教授,有着丰富的临床经验,技术全面。任广东省医学会眼科分会委员,广州市医学会眼科分会常委,花都区医学会眼科专业委员会主委。擅长白内障超声乳化手术,处理各种复杂白内障病例,对青光眼、眼外伤、外眼整形、泪道手术等手术及眼表疾病、葡萄膜、视神经炎、眼底病、儿童及青少年斜弱视屈光不正等疾病的治疗亦较有心得。
眼科简介

广州市花都区人民医院眼科成立于1991年,是集临床教学、科研于一体的综合性科室。科室下设眼底病亚专科和青少年近视矫正亚专科。科室现有主任医师1人,副主任医师2人,主治医师4人,住院医师2人,其中5人拥有硕士学位。
目前,科室主要诊疗项目包括:白内障超声乳化联合人工晶体植入术、青光眼手术、视网膜脱离及玻璃体切割手术、各类眼外伤手术、泪道手术、眼部肿瘤手术以及眼部整形美容手术。同时,科室还开展各类激光治疗(如眼底疾病、后发性白内障及青光眼的激光治疗),各项技术均达到国内及省内先进水平。此外,科室还对眼表病、视神经病变及葡萄膜病变等眼内科疾病有丰富诊治经验。同时,眼科是多家医学院校的实习基地,承担了多项省市区级科研课题,并在国家级和省级期刊上发表论文数十篇。2010年,科室荣获地级市科学技术进步二等奖,另有两项课题获得区科技进步奖。
文、图|王沫依 刘聪